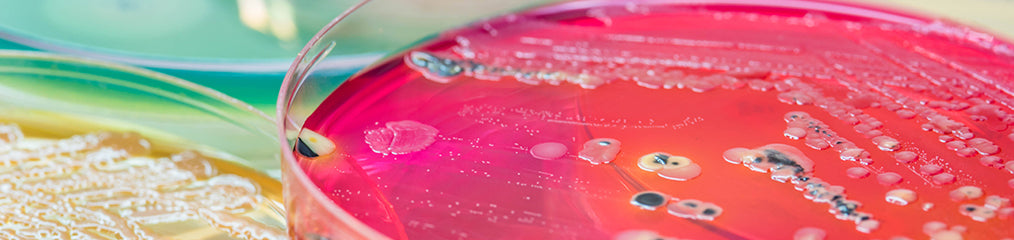
A Guide for Choosing Between Commonly Used Antibiotics

What is a BSE/TSE Certificate and Why Should You Care?
TSE Certificates (Transmissible Spongiform Encephalopathy) come packaged with products that could potentially have TSE risk, such as BSA (Bovine Serum Albumin), but some people don’t...


TSE Certificates (Transmissible Spongiform Encephalopathy) come packaged with products that could potentially have TSE risk, such as BSA (Bovine Serum Albumin), but some people don’t...

With tenure track positions being few and far between and thousands of applicants to each position that opens, successfully getting a permanent position as a...

All right, so you’re starting a new project that requires you to use the luciferase assay, and this is your first time. You might have...

Any type of interview can be nerve-wracking and post-doctoral interviews are no exception. While they typically include the traditional interview where you allow the interviewer(s)...

Life science labs come in many varieties. Some are small with just a couple people and some are very large. According to Nature, the ideal...

Whether you’re already in graduate school or you’re an undergrad who will be joining a Ph.D. program soon, you probably have questions about publishing papers....

Ethidium bromide (EtBr) has been the go-to product for nucleic acid staining; however, you’re probably well aware of the risks involved in using this chemical....
IPTG induction is a longstanding technique in molecular biology. In this article, you’ll take a deep dive into this important application. You will learn what...

Many biological experiments require the use of buffers to maintain an effective pH, which is important since proteins and enzymes are sensitive to changes in...

When working in the life sciences, what we know is always changing. New discoveries are made, new technologies are invented, and we have to adapt....
When it comes to choosing between common research antibiotics, there are a few guidelines that can help you make a decision. The most important deciding...

inding the perfect piece of lab equipment to buy can be quite the task. These 10 tips will help you make the decision between purchasing...
